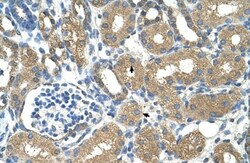
alcohol dehydrogenase 4 Antibody, Novus Biologicals 100&mu;L; Unlabeled:Antibodies,

missing translation for 'onlineSavingsMsg'
Learn More
Learn More
alcohol dehydrogenase 4 Antibody, Novus Biologicals™
Rabbit Polyclonal Antibody
Brand: Novus Biologicals NBP1-53173
This item is not returnable.
View return policy
Description
alcohol dehydrogenase 4 Polyclonal specifically detects alcohol dehydrogenase 4 in Human samples. It is validated for Western Blot, Immunohistochemistry, Immunohistochemistry-Paraffin.
Specifications
| alcohol dehydrogenase 4 | |
| Polyclonal | |
| Unconjugated | |
| PBS, 2% Sucrose with 0.09% Sodium Azide | |
| ADH-2, alcohol dehydrogenase 4, alcohol dehydrogenase 4 (class II), pi polypeptide, Alcohol dehydrogenase class II pi chain, aldehyde reductase, EC 1.1.1, EC 1.1.1.1 | |
| Rabbit | |
| Protein A purified | |
| RUO | |
| Primary | |
| Centrifuge the vial of lyoph antibody at 12,000 x g for 20 seconds. Add 100μL of distilled water. Vortex followed by centrifuge again to pellet the solution.Final concentration is 1mg/mL in PBS buffer. | |
| Store at 4°C short term. Aliquot and store at -20°C long term. Avoid freeze-thaw cycles. | |
| IgG |
| Western Blot, Immunohistochemistry, Immunohistochemistry (Paraffin) | |
| 1 mg/ml | |
| Western Blot 1.0 ug/ml, Immunohistochemistry 1:10-1:500, Immunohistochemistry-Paraffin 1:10-1:500 | |
| P08319 | |
| ADH4 | |
| Synthetic peptides corresponding to ADH4(alcohol dehydrogenase 4 (class II), pi polypeptide) The peptide sequence was selected from the middle region of ADH4. Peptide sequence NSEKFVKAKALGATDCLNPRDLHKPIQEVIIELTKGGVDFALDCAGGSET. | |
| 100 μL | |
| Lipid and Metabolism | |
| 127 | |
| Human, Rat, Pig, Bovine, Canine, Rabbit | |
| Purified |
Product Content Correction
Your input is important to us. Please complete this form to provide feedback related to the content on this product.
Product Title
Spot an opportunity for improvement?Share a Content Correction